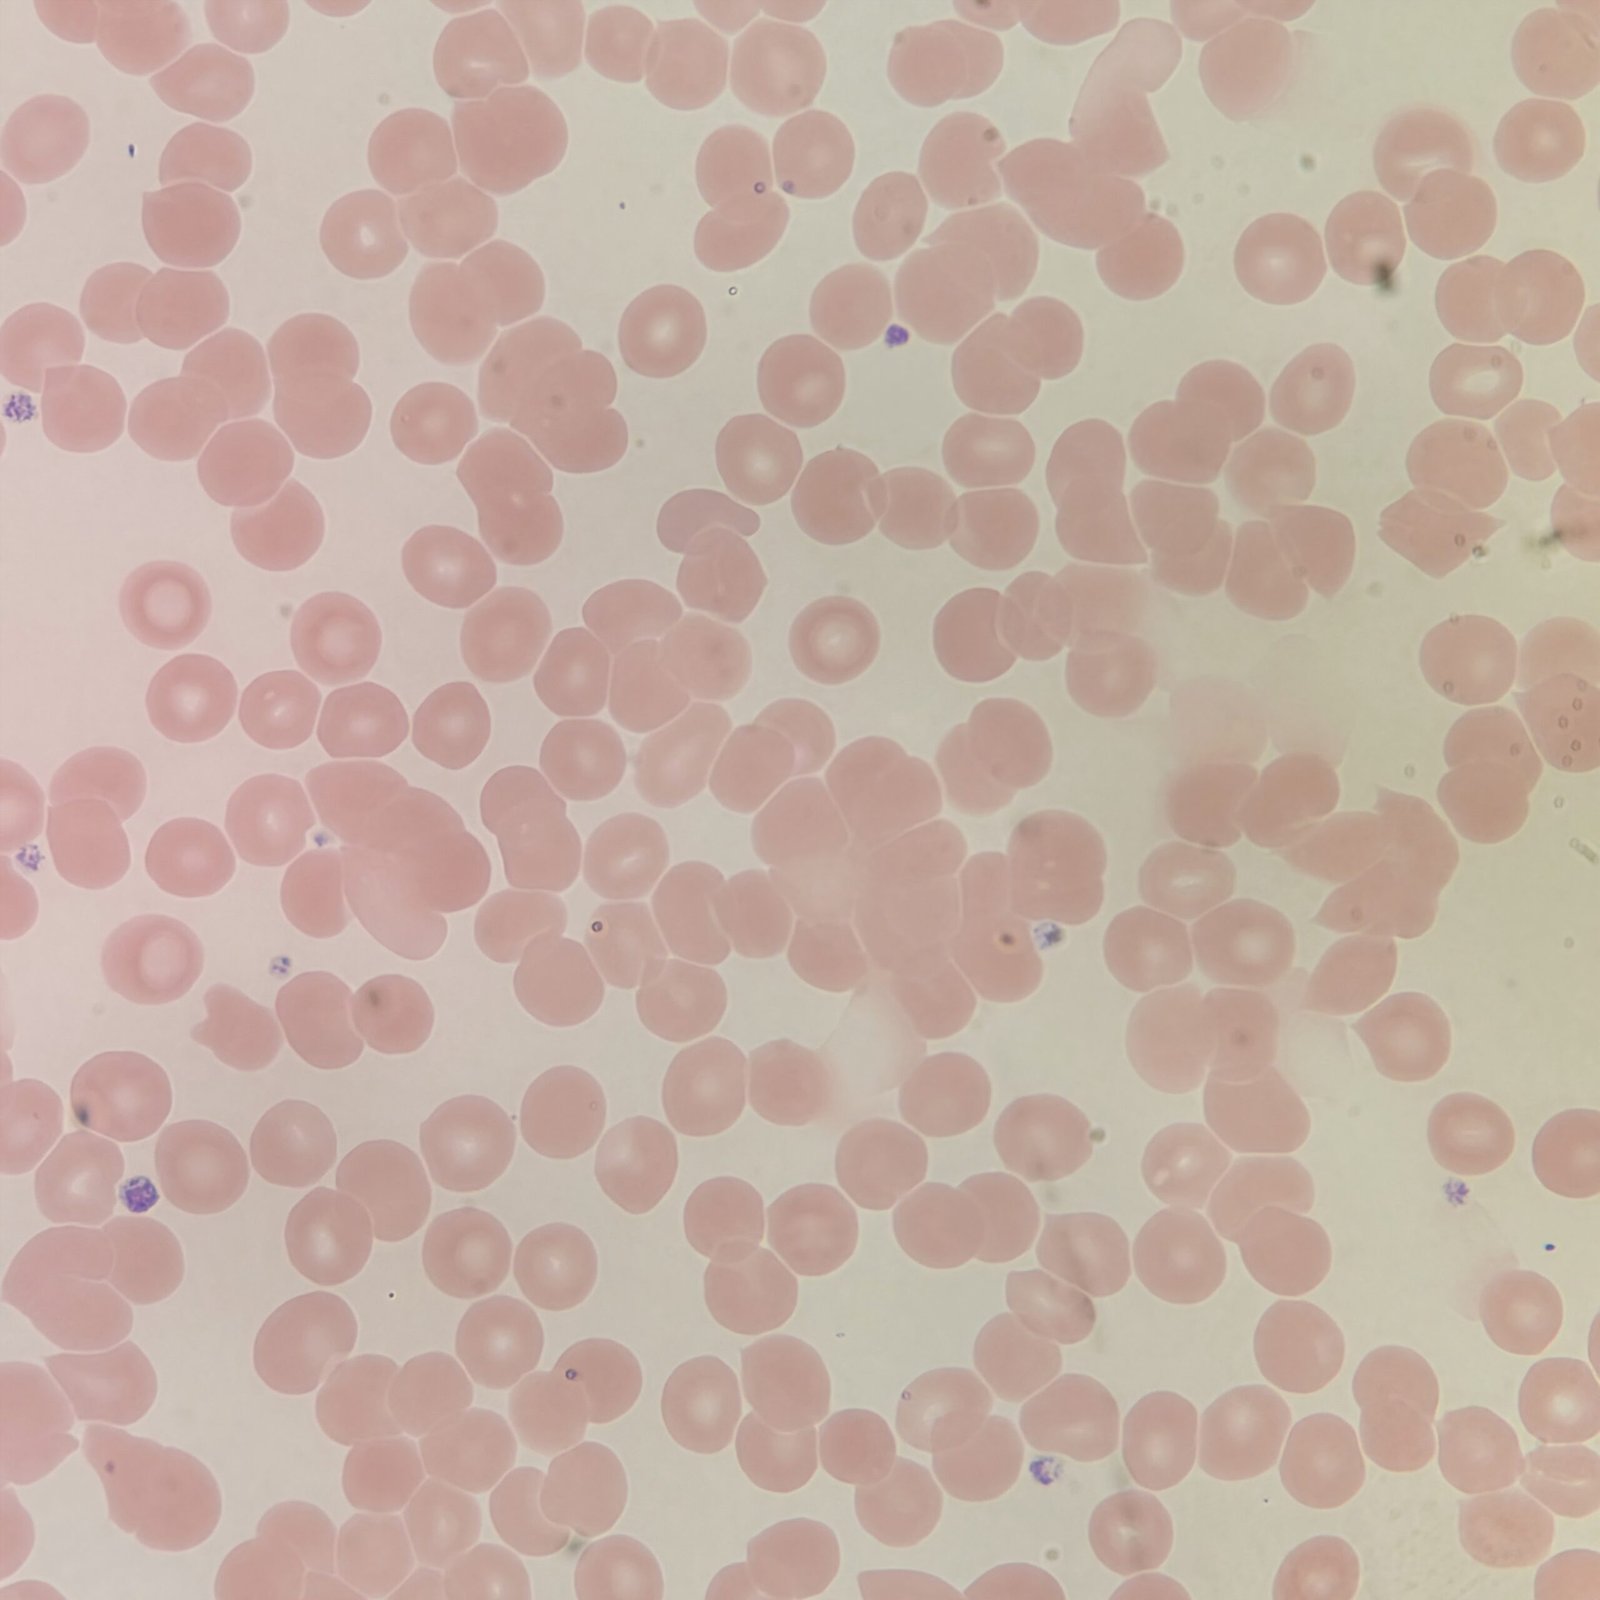
Red blood cells on a slide agglutinating/clumping together from a cold agglutinin.

Rouleaux is caused by increased plasma proteins allowing red blood cells to stack together. In most cases, this protein is excess fibrinogen due to pregnancy or inflammation. Pathologically, plasma cells in multiple myeloma produce excess immunoglobulins. Cells can be seen stacking together normally in thicker areas of the slide.
Saline replacement can be used to correct rouleaux if indices are affected.
Macroscopic Appearance
Excess proteins in the blood may cause the slide to stain more blue than usual. Compare the two slides in the image on the right. The left slide is on a patient with significant rouleaux while the right slide is on a normal patient. The blue shade on the left slide is readily apparent.

Microscopic Appearance
With rouleaux, red blood cells stack together like coins in a linear fashion. Individual cells in the stack can be identified.

Lookalikes
Agglutination can be mistaken for rouleaux. With agglutination however, cells are clumped together instead of appearing linearly.
Agglutination
Gallery











